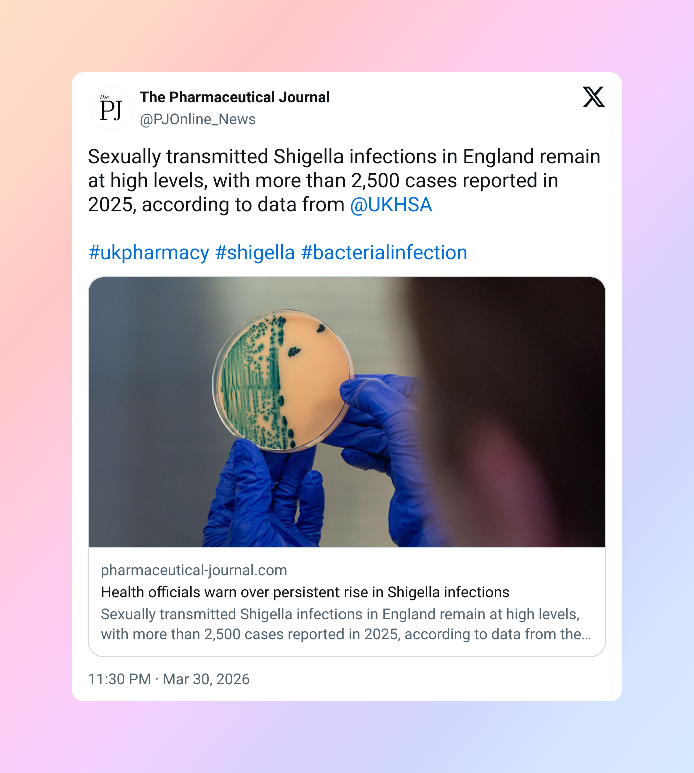
shigella

Shigella infections are on the rise—and according to a report from the UK Health Security Agency, the increase is being seen particularly among gay, bisexual men, and men who have sex with men (GBMSM).

In 2025 alone, England recorded 2,560 cases, with a noticeable pattern: cases among adult men without recent travel history have been rising faster than in other groups. This suggests that many infections are being transmitted locally, including through sexual contact.
While this might sound alarming, understanding how Shigella spreads and how to protect yourself can make a big difference.
What Is Shigella and How Is It Transmitted?
Shigella is a type of bacterial infection that affects the intestines most commonly. There are several strains, but the ones most commonly linked to sexual transmission are S. sonnei and S. flexneri.
The key thing to know is that Shigella spreads through the faecal-oral route. In everyday terms, this means the bacteria can be passed on when tiny amounts of infected fecal matter enter the mouth—something that can happen during certain types of sexual activity, particularly those involving oral-anal contact.
While Shigella can also be contracted through contaminated food or water—especially when traveling to countries where the bacteria is more common—the current rise in England is largely tied to local, sexually transmitted cases.
RELATED: Our Top Tips for First Time Anal Sex
Why Cases Are Increasing
The report notes that increases in sexually transmitted Shigella were first observed in 2022 and have continued to rise since then.
Geographically, the highest number of cases in 2025 were reported in London (54%), followed by Thames Valley and Surrey, and Sussex.
Another major concern is antimicrobial resistance. Over half of S. sonnei samples in 2025 were classified as extensively drug-resistant, meaning they may not respond to standard first-line treatments.
This makes prevention and proper medical care even more important.
Symptoms to Watch Out For
Shigella infections can range from mild to severe. Common symptoms include but are not limited to:
- Diarrhea (mild, self-limited to severe and/or bloody)
- Stomach cramps
- Fever
Some people may experience only mild symptoms, while others can feel significantly unwell. If you notice these signs—especially after recent sexual contact—it’s important to seek medical advice.
Avoid self-medicating or taking random antibiotics, as this can contribute to further drug resistance and may not treat the infection properly.
Prevention: What You Can Do
The good news is that Shigella is preventable with a few practical steps.
Good hygiene during and after sex plays a major role. This includes washing hands, genitals, and any shared items thoroughly. Using condoms and barriers can also reduce risk.
If you’re feeling unwell, it’s best to avoid sexual activity until you’ve fully recovered. Health guidance recommends waiting at least 7 days after your last symptom before having sex again.
RELATED: PrEP and Cancer Screenings Stay Free, SCOTUS Rules
Testing and Looking After Your Health
If you’re diagnosed with Shigella, rest and hydration are key to recovery. Just as important is getting a full sexual health screening, as exposure to Shigella can sometimes overlap with other sexually transmitted infections, including HIV.
For many in the LGBTQ community, there can be hesitation around discussing symptoms—but early diagnosis not only helps you recover faster, it also helps prevent passing the infection on to others.
The Bottom Line
The rise in Shigella cases—especially drug-resistant strains—is something the LGBTQ community should be aware of, but not panic over.
With awareness, proper hygiene, and timely medical care, the risks can be managed effectively. Staying informed, getting tested when needed, and taking care of your body are all part of protecting both yourself and your partners.
And as always: if something feels off, it’s better to check than to guess.
REFERENCE: UK Health Security Agency